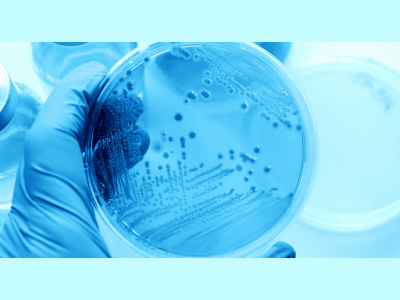

La Microbiología es la ciencia responsable del estudio de los diferentes grupos de microorganismos. Proporciona al estudiante conocimientos sobre la morfología, fisiología, factores de virulencia, patogénesis y control de los microorganismos, relacionándolos con procesos infecciosos de interés médico-veterinario, así como las técnicas para realizar un diagnóstico microbiológico.
Existen diversas técnicas de laboratorio y reactivos específicos que son muy útiles en la investigación. Este curso provee herramientas fundamentales para el conocimiento de la dinámica de bacterias y hongos, así como proporciona conocimientos para la comprensión de las enfermedades infecciosas producidas por estos agentes.
Existen diversas técnicas de laboratorio y reactivos específicos que son muy útiles en la investigación. Este curso provee herramientas fundamentales para el conocimiento de la dinámica de bacterias y hongos, así como proporciona conocimientos para la comprensión de las enfermedades infecciosas producidas por estos agentes.
- Profesor: Iris Betania Rivera Cruz
